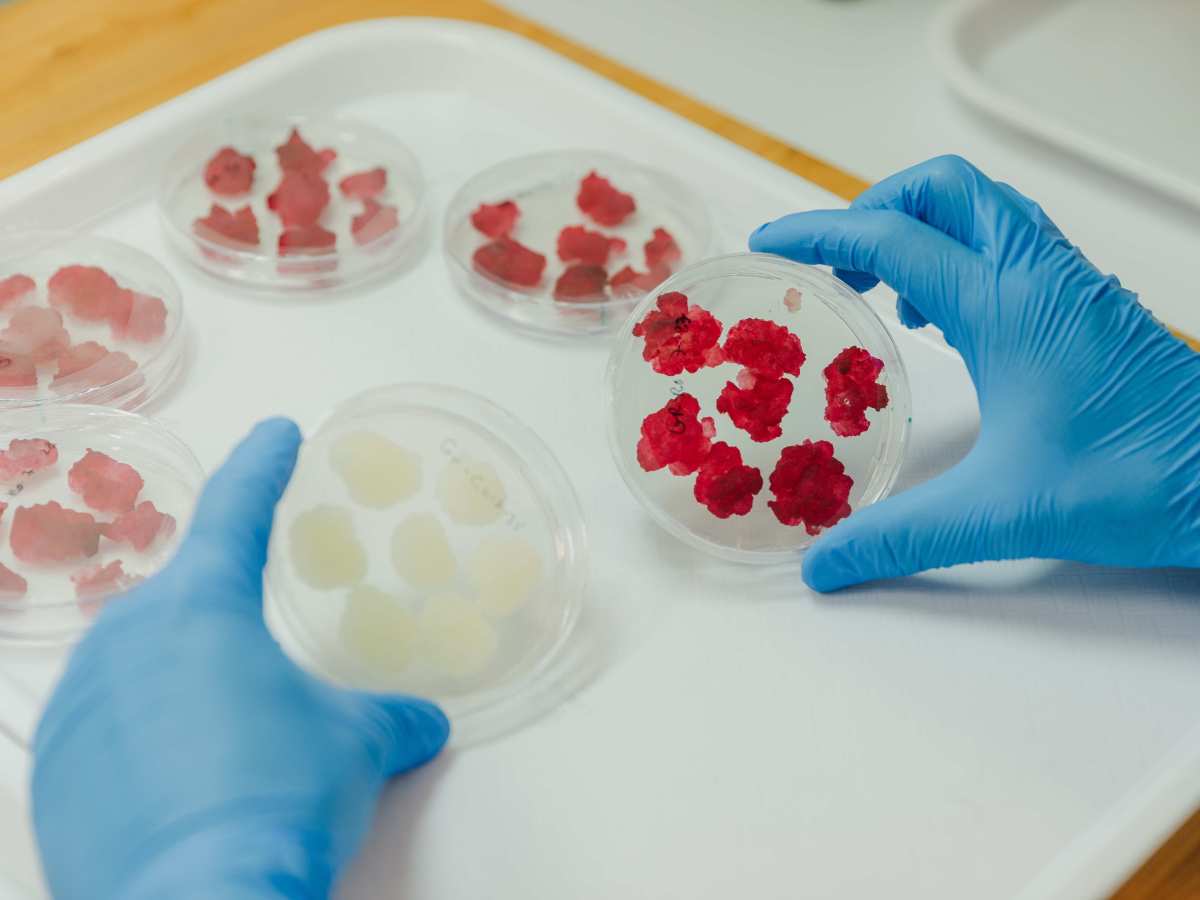
New CEO to drive global commercialization of precision botanical ingredients for the nutraceutical&nbsp;industry

China’s €11B Wood and Rubber Trade Faces Growing Pressure as Global Buyers Demand Supply Chain Traceability
Global trade in forest-risk commodities is entering a new era, defined not by scale alone, but by the ability to prove origin through verifiable supply chain traceability. For China, the world’s largest processor and exporter of wood and rubber derived goods, the implications are immediate and structural. China exports over €7.1 billion in wood-based goods and…
continue readingPACE launches Europe’s first full-scale retrofitted biorefinery to transform potato juice into sustainable bio-based chemicals
A new European flagship project is set to demonstrate at industrial scale, how an underutilized side-stream from the potato processing industry can become a valuable source of sustainable chemicals. PACE (Potato Juice to Fatty Acids for New Bio-based Value-Chains in Europe) will demonstrate a first-of-its-kind flagship biorefinery by retrofitting part of Royal Avebe’s existing production…
continue readingBrevel, Coffeesai Team Up to Optimize Production with Illuminated Fermentation
Brevel, Ltd. enters fully into the plant cell-culture market to help companies scale-up production and enhance nutrients yield, utilizing its proprietary illuminated fermentation platform. Brevel is partnering with Coffeesai, a coffee cell-culture company to use light as a key factor in promoting the growth of coffee cells, and accelerate the transition from lab to commercial…
continue readingFresh-Frozen Herbs Get a Makeover with a Soft, Scoopable Format
Kad Bnei Darom, Ltd., with more than a half century in herb and vegetable processing, launches a leap forward in fresh-frozen herbs. Kad has crafted a new line of frozen herbs in 200 ml containers. The herbs scoop effortlessly straight from the freezer. Kad also introduces popular spreads, traditionally sold in the refrigerated aisle, into…
continue readingFuture Fit Asia Announces Two Winners of Inaugural Grantham Foundation Detox Awards, sharing USD 90,000 in Prizes, at Landmark 10th Edition
Future Fit Asia (formerly Future Food Asia) concluded its landmark 10th edition conference on 13 May 2026 at Goodwood Park Hotel, Singapore, with the announcement of the winners of the inaugural Grantham Foundation Detox Awards. Pandawa Agri Indonesia (Indonesia) for their technology to reduce herbicide use, and Prof. Eric Chan and Dr. Dachuan Zhang (Bezos…
continue readingNew Frozen Herb Pops Redefines Convenience and Sustainability
Agrifood company Kad Bnei Darom introduces Cuca™ Herb Pops, its fresh contribution to the culinary domain. These highly practical, innovative herb pops present a new format for flash-frozen fresh herbs that merge convenience with eco-consciousness. The company will reveal the new product line at the Fancy Food Show in New York, 28-30 June 2026. In…
continue reading
UK-developed biostimulant gains international attention as SugaROx joins inaugural cohort of US-based agri-tech programme
UK crop biostimulant developer SugaROx has been selected for the inaugural H.A.R.V.E.S.T. AgTech programme, a global initiative led by The Yield Lab Institute in the US to accelerate the development and commercialisation of next-generation agricultural technologies. The Harpenden-based venture is one of just seven companies chosen globally, reflecting growing international interest in its technology for…
continue readingUK Aquaculture Pioneer – Three-Sixty Aquaculture – Expands Into Europe with Launch of New Land-Based Prawn Farm
Three-Sixty Aquaculture, the UK’s sushi‑grade prawn specialists backed by renowned British chef, Marcus Wareing, has announced its first major European expansion with the construction of a new indoor prawn farm in Oostende, Belgium. This milestone, made possible by support from Marifish.Inc – the Belgian incubator for emerging fisheries and aquaculture businesses – marks a significant…
continue readingSweet Victory Gum Helps Type 1 Diabetics Halve Sweets Snacking in Pilot Clinical Trial
Results of a new clinical pilot study reveal that chewing Sweet Victory gum could help patients with type 1 diabetes (T1DM) reduce sweet snacking by more than half. The functional chewing gum, formulated with powdered leaves of the Gymnema sylvestre plant was designed by Sweet Victory, Ltd. to help consumers strengthen their resistance to sugary…
continue readingACTEGA and Living Ink Technologies, in Partnership with Waiākea Hawaiian Volcanic Beverages, Develop First UV Flexographic Ink for CPG Labels Made with Carbon-Negative, Algae-Based Pigment
ACTEGA, a global specialist in inks and coatings, and Living Ink Technologies, a leader in bio-based pigment innovation, have announced the launch of ACTExact® UV Black Algae Ink, the first commercially available UV flexographic ink formulated with carbon-negative Algae Black™ pigment. The launch comes in tandem with its first commercial application: beverage labels printed by…
continue readingNew CEO to drive global commercialization of precision botanical ingredients for the nutraceutical industry
Novella Innovative Technology, Ltd., an innovator in plant-cell-based ingredients, announces the appointment of Antonio Martinez Descalzo, a global expert in scaling health and wellness ingredients as company CEO. The biotech and nutrition veteran will lead the start-up’s transition from its intensive R&D phase toward full-scale commercial operation. Martinez brings more than two decades of global…
continue readingNew Wave Biotech and iMEAN Announce First Cell-to-Product AI Optimisation Solution for Biomanufacturing
New Wave Biotech and iMEAN have partnered to offer biomanufacturers a pioneering combined solution for end-to-end bioprocess optimisation, combining New Wave’s downstream process, TEA and LCA modelling capabilities with iMEAN’s strain design and upstream process modelling expertise. The EU Biotech Act, US BIOSECURE Act and China’s Five-Year Plan are all accelerating demand for sovereign biomanufacturing…
continue reading